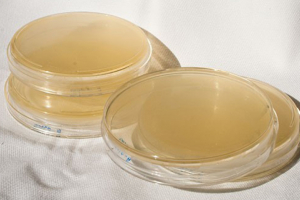

Near Infrared (NIR)
Near Infrared (NIR) Suppliers
Specac makes ATRs, transmission cells, gas cells, and other accessories for FTIR spectroscopy and near infrared (NIR) process spectroscopy. We also manufacture hydraulic presses for…
ABB’s portfolios of high performance laboratory, at-line and process FT-IR/FT-NIR analyzers address a wide variety of applications. Our spectrometers perform real-time analysis of the…
The Starna Group is the world’s leading supplier of Certified Reference Materials for UV-Visible and NIR spectrophotometry, spectrophotometer cells, sampling accessories and optical…